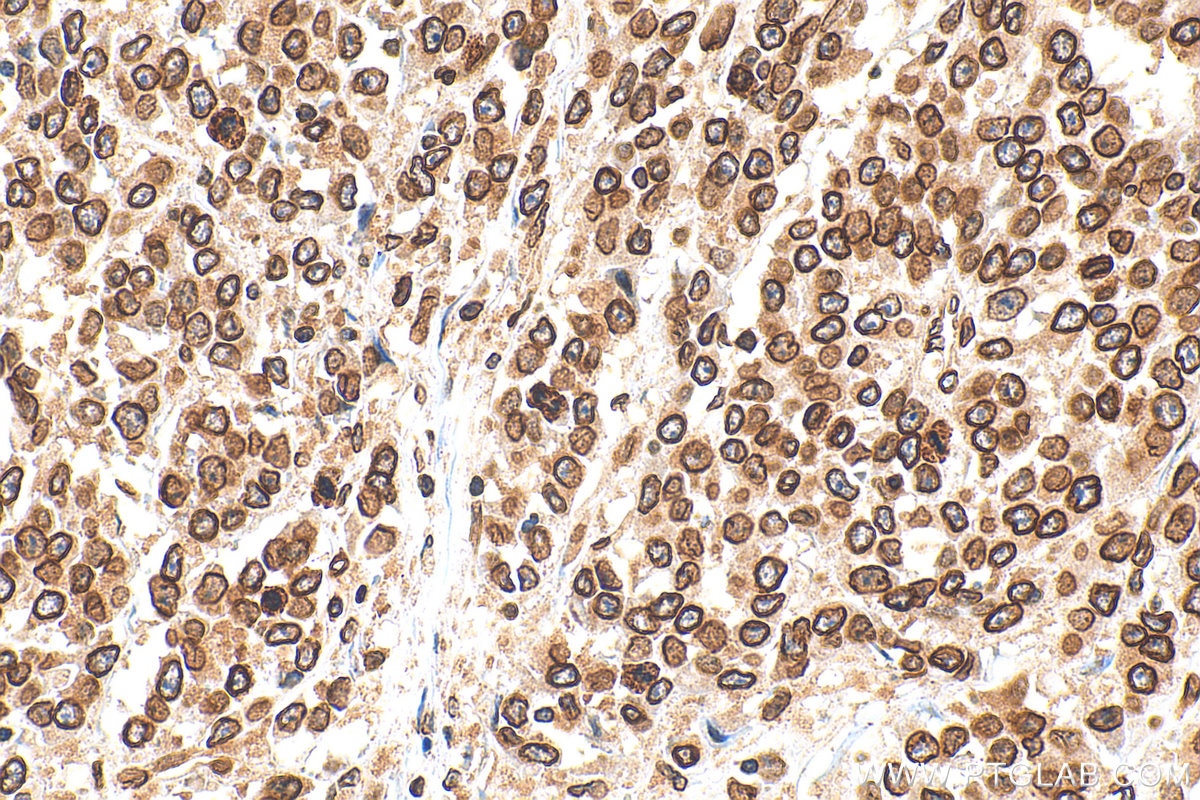
Immunohistochemistry (IHC) staining of human colon cancer tissue using Lamin B1 Polyclonal antibody (12987-1-AP)

"Lamin B1 Antibodies" Comparison
View side-by-side comparison of Lamin B1 antibodies from other vendors to find the one that best suits your research needs.
Tested Applications
| Positive WB detected in | HeLa cells, HepG2 cells, Jurkat cells, MCF-7 cells, NIH/3T3 cells, K-562 cells, RAW 264.7 cells |
| Positive IP detected in | HeLa cells |
| Positive IHC detected in | mouse heart tissue, human colon tissue, human colon cancer tissue, human hepatocellular carcinoma, mouse kidney tissue Note: suggested antigen retrieval with TE buffer pH 9.0; (*) Alternatively, antigen retrieval may be performed with citrate buffer pH 6.0 |
| Positive IF-P detected in | human skin cancer tissue |
| Positive IF/ICC detected in | HepG2 cells, NIH/3T3 cells |
| Positive FC (Intra) detected in | HEK-293 cells |
Recommended dilution
| Application | Dilution |
|---|---|
| Western Blot (WB) | WB : 1:5000-1:50000 |
| Immunoprecipitation (IP) | IP : 0.5-4.0 ug for 1.0-3.0 mg of total protein lysate |
| Immunohistochemistry (IHC) | IHC : 1:1000-1:4000 |
| Immunofluorescence (IF)-P | IF-P : 1:50-1:500 |
| Immunofluorescence (IF)/ICC | IF/ICC : 1:200-1:800 |
| Flow Cytometry (FC) (INTRA) | FC (INTRA) : 0.40 ug per 10^6 cells in a 100 µl suspension |
| It is recommended that this reagent should be titrated in each testing system to obtain optimal results. | |
| Sample-dependent, Check data in validation data gallery. | |
Published Applications
| KD/KO | See 6 publications below |
| WB | See 1275 publications below |
| IHC | See 11 publications below |
| IF | See 70 publications below |
| IP | See 2 publications below |
| CoIP | See 1 publications below |
| ChIP | See 4 publications below |
Product Information
12987-1-AP targets Lamin B1 in WB, IHC, IF/ICC, IF-P, FC (Intra), IP, CoIP, ChIP, ELISA applications and shows reactivity with human, mouse, rat samples.
| Tested Reactivity | human, mouse, rat |
| Cited Reactivity | human, mouse, rat, pig, canine, monkey, chicken, hamster, escherichia coli, bombyx mori |
| Host / Isotype | Rabbit / IgG |
| Class | Polyclonal |
| Type | Antibody |
| Immunogen |
CatNo: Ag3631 Product name: Recombinant human Lamin B1 protein Source: e coli.-derived, PGEX-4T Tag: GST Domain: 237-587 aa of BC012295 Sequence: EYEYKLAQALHEMREQHDAQVRLYKEELEQTYHAKLENARLSSEMNTSTVNSAREELMESRMRIESLSSQLSNLQKESRACLERIQELEDLLAKEKDNSRRMLTDKEREMAEIRDQMQQQLNDYEQLLDVKLALDMEISAYRKLLQGEEERLKLSPSPSSRVTVSRASSSRSVRTTRGKRKRVDVEESEASSSVSISHSASATGNVCIEEIDVDGKFIRLKNTSEQDQPMGGWEMIRKIGDTSVSYKYTSRYVLKAGQTVTIWAANAGVTASPPTDLIWKNQNSWGTGEDVKVILKNSQGEEVAQRSTVFKTTIPEEEEEEEEAAGVVVEEELFHQQGTPRASNRSCAIM Predict reactive species |
| Full Name | lamin B1 |
| Calculated Molecular Weight | 66 kDa |
| Observed Molecular Weight | 66-70 kDa |
| GenBank Accession Number | BC012295 |
| Gene Symbol | Lamin B1 |
| Gene ID (NCBI) | 4001 |
| ENSEMBL Gene ID | ENSG00000113368 |
| RRID | AB_2136290 |
| Conjugate | Unconjugated |
| Form | Liquid |
| Purification Method | Antigen affinity purification |
| UNIPROT ID | P20700 |
| Storage Buffer | PBS with 0.02% sodium azide and 50% glycerol, pH 7.3. |
| Storage Conditions | Store at -20°C. Stable for one year after shipment. Aliquoting is unnecessary for -20oC storage. 20ul sizes contain 0.1% BSA. |
Background Information
Lamins are components of the nuclear lamina, a fibrous layer on the nucleoplasmic side of the inner nuclear membrane, which is thought to provide a framework for the nuclear envelope and may also interact with chromatin. The nuclear lamina consists of a two-dimensional matrix of proteins located next to the inner nuclear membrane. The lamin family of proteins make up the matrix and are highly conserved in evolution. During mitosis, the lamina matrix is reversibly disassembled as the lamin proteins are phosphorylated. Vertebrate lamins consist of two types, A and B. This gene encodes one of the two B type proteins, B1. Expression of uncleavable mutant lamin A or B caused significant delays in the onset of chromatin condensation and nuclear shrinkage during apoptosis (PMID:11953316). This protein is not suitable for samples where the nuclear envelope has been removed.
Protocols
| Product Specific Protocols | |
|---|---|
| FC protocol for Lamin B1 antibody 12987-1-AP | Download protocol |
| IF protocol for Lamin B1 antibody 12987-1-AP | Download protocol |
| IHC protocol for Lamin B1 antibody 12987-1-AP | Download protocol |
| IP protocol for Lamin B1 antibody 12987-1-AP | Download protocol |
| WB protocol for Lamin B1 antibody 12987-1-AP | Download protocol |
| Standard Protocols | |
|---|---|
| Click here to view our Standard Protocols |
Publications
| Species | Application | Title |
|---|---|---|
Nat Biotechnol Drag-and-drop genome insertion of large sequences without double-strand DNA cleavage using CRISPR-directed integrases | ||
Cell Res Disruption of ER ion homeostasis maintained by an ER anion channel CLCC1 contributes to ALS-like pathologies | ||
Nature Stella safeguards the oocyte methylome by preventing de novo methylation mediated by DNMT1. | ||
Mol Cancer Diversifying the anthracycline class of anti-cancer drugs identifies aclarubicin for superior survival of acute myeloid leukemia patients | ||
Immunity 25-Hydroxycholesterol regulates lysosome AMP kinase activation and metabolic reprogramming to educate immunosuppressive macrophages |
Reviews
The reviews below have been submitted by verified Proteintech customers who received an incentive for providing their feedback.
FH Sai Sindhura (Verified Customer) (12-22-2025) | This antibody is working very good
|
FH Rajkumar (Verified Customer) (04-18-2025) | I used this antibody for HRP-based detection and it worked very well at the suggested dilution. The signal was strong. Highly recommend for similar applications.
|
FH Mi (Verified Customer) (02-21-2023) | Works great in human adipocytes.
|
FH Ning (Verified Customer) (01-28-2023) | Excellent antibody to probe lamin B1.
![]() |
FH Tsimafei (Verified Customer) (12-04-2022) | 20µg of total protein were loaded. Incubation for 2h at room temperature. Excellent antibody
![]() |
FH Alejandro (Verified Customer) (08-07-2022) | Works fine for flow cytometry
|
FH Iram (Verified Customer) (09-04-2020) | Very sharp bands for nuclear protein
|
FH Chun (Verified Customer) (12-05-2019) | Excellent antibody
|
FH Marco (Verified Customer) (09-02-2019) | good staining in conjunction with Alexa Fluor Plus 488 secondary
|